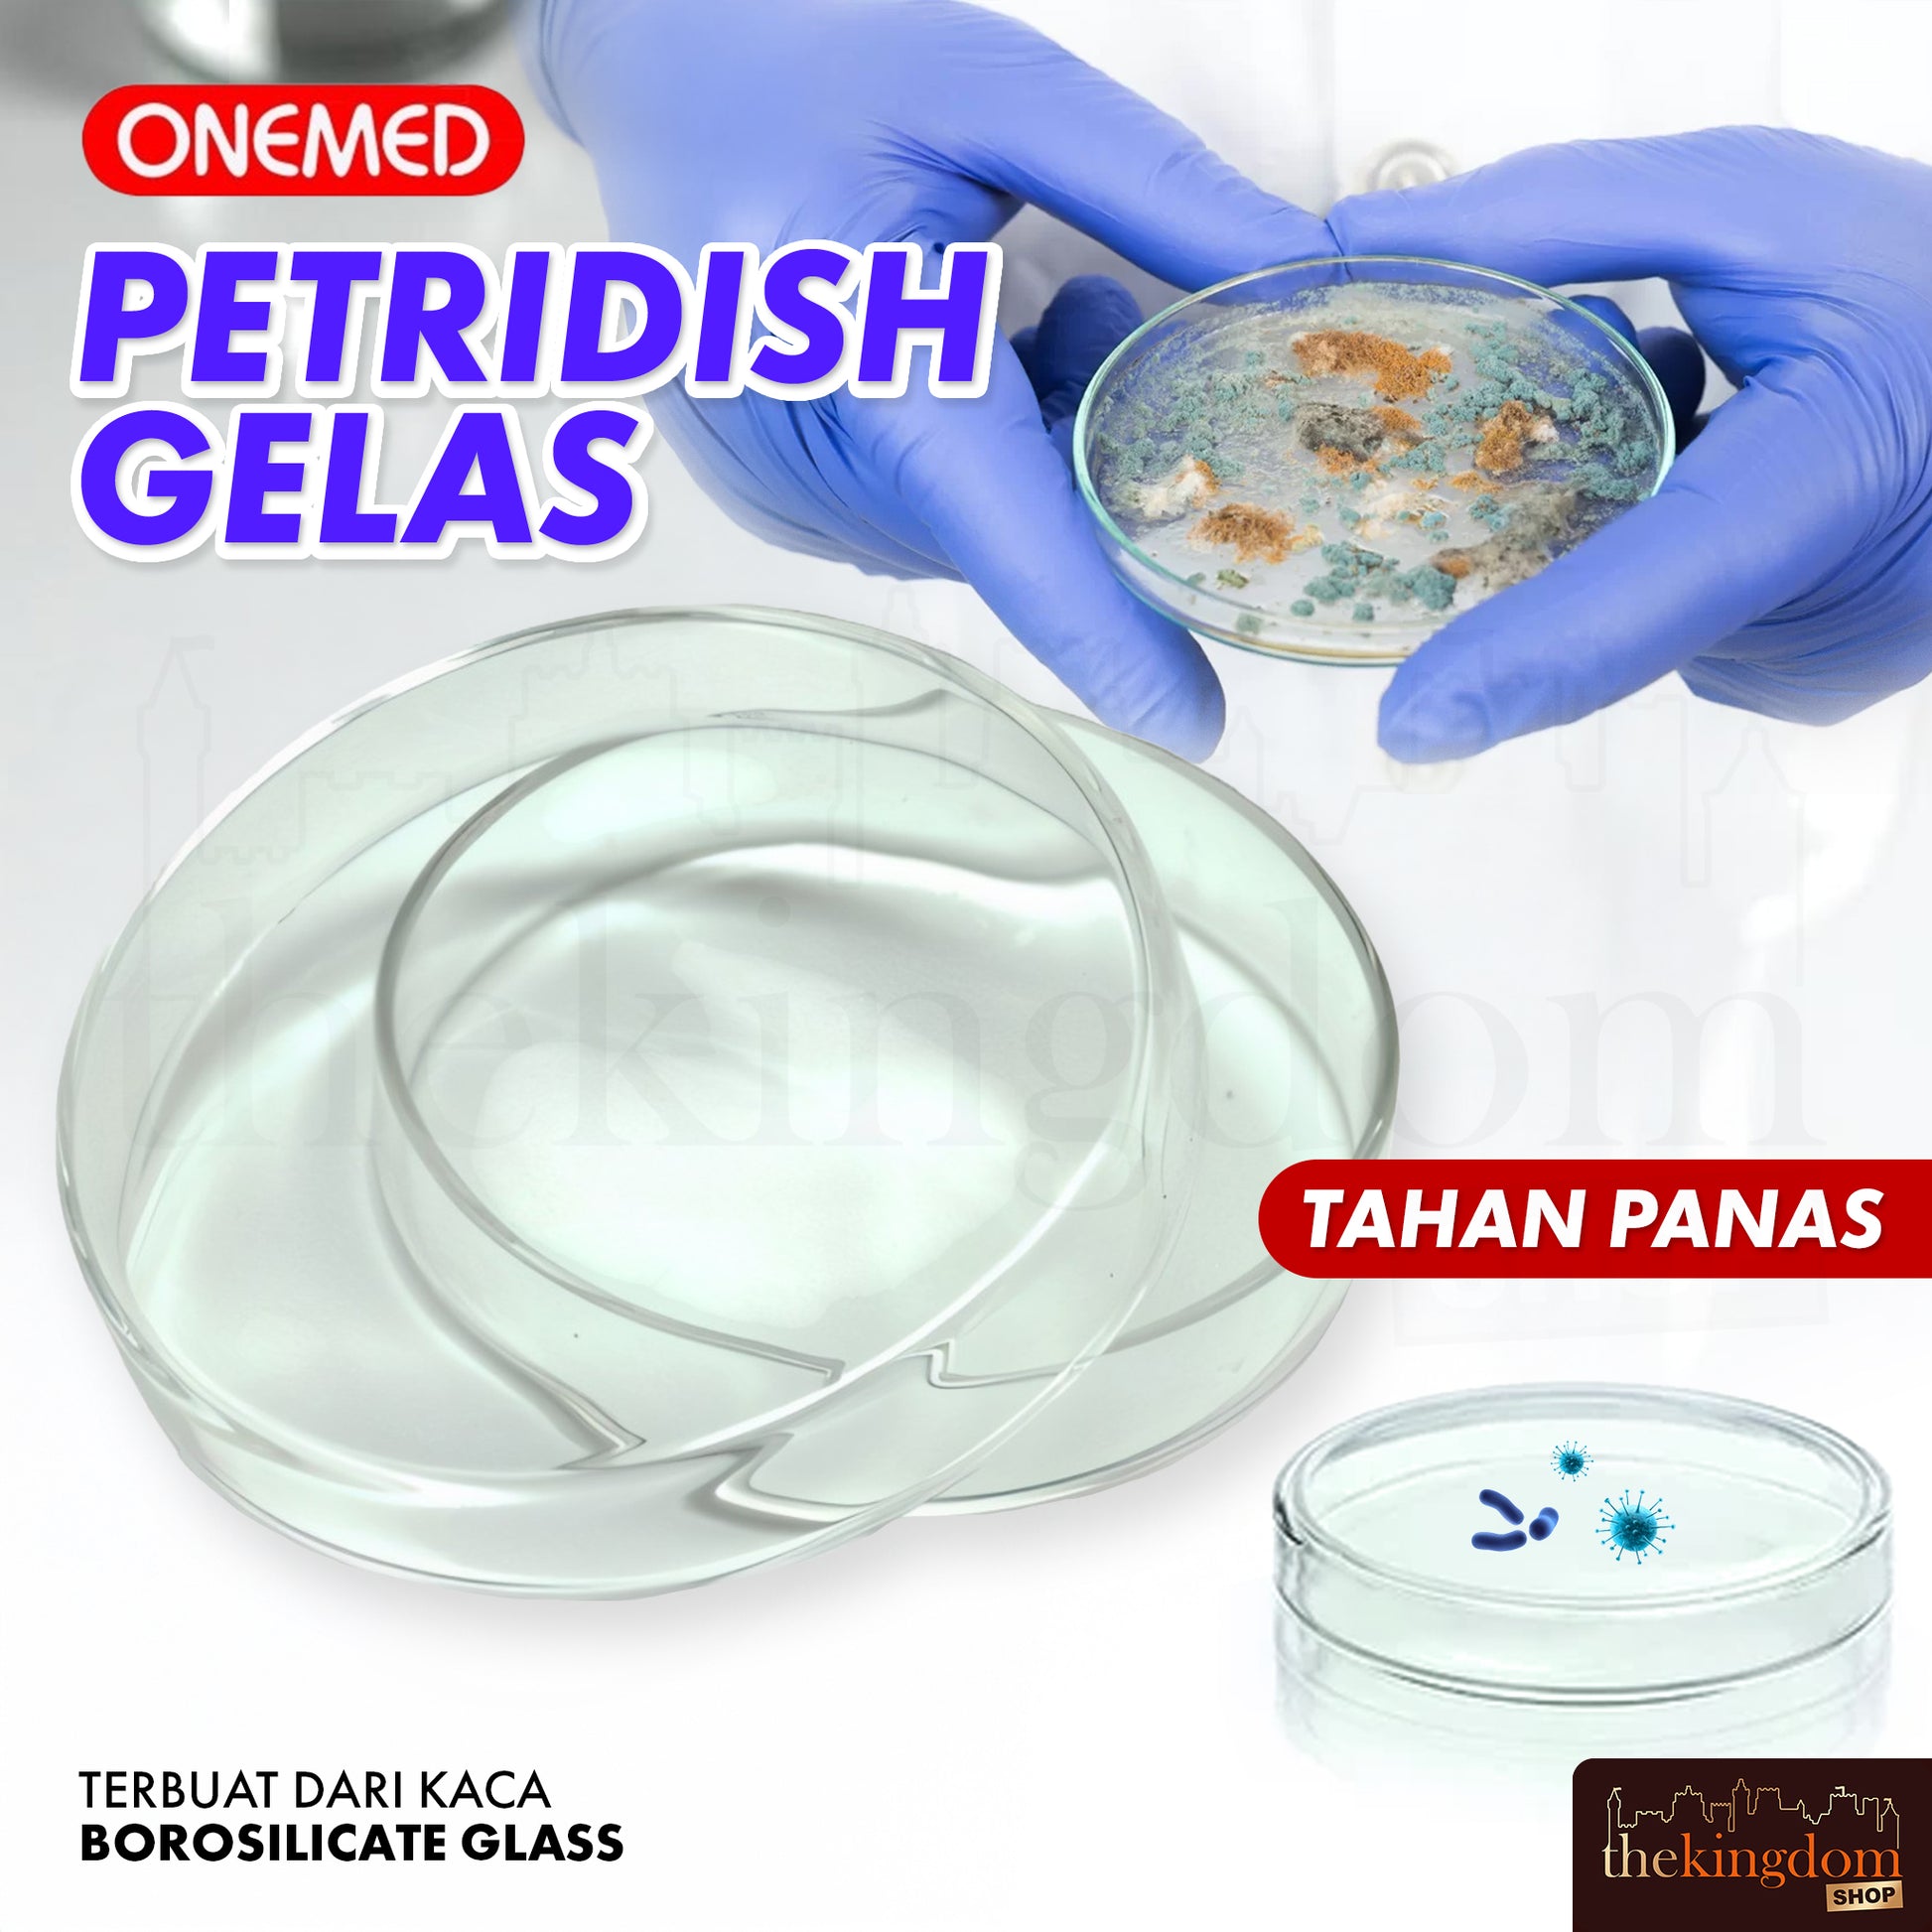

-36%
Onemed Petridish Glass
Regular price
Rp 11.500
Sale price
Rp 18.000
Open Monday-Saturday 9-5pm. Sunday/red holiday. We process all orders during working hours.
Please do an unboxing video when receiving the package.
- Sku: 111841
- Available: outstock
- Vendor: Onemed
- Type: Petridish
- Collections: Spare Parts: Medical Equipment















